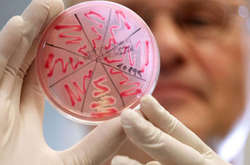
В Одесі знижується захворюваність на ГРВІ та грип

Під Одеською облрадою мітингували проти Сігала і Ройтбурда

Два мітинги на одній площі
Сьогодні під будівлею Одеської обласної ради зібралися мітингувальники - у зв'язку з сесією облради вони протестували проти одного художника і одного місцевого депутата.
В Одесі проходить перша в цьому році сесія Одеської обласної ради. Саме тому під будівлею незадовго до початку зібралися мітингувальники.
Мітингів два: один проти призначення художника Олександра Ройтбурда на посаду директора Художнього музею, другий же - проти представника «Оппоблока» в Роздільнянському районі Фелікса Сігала.

Коментарі — 0